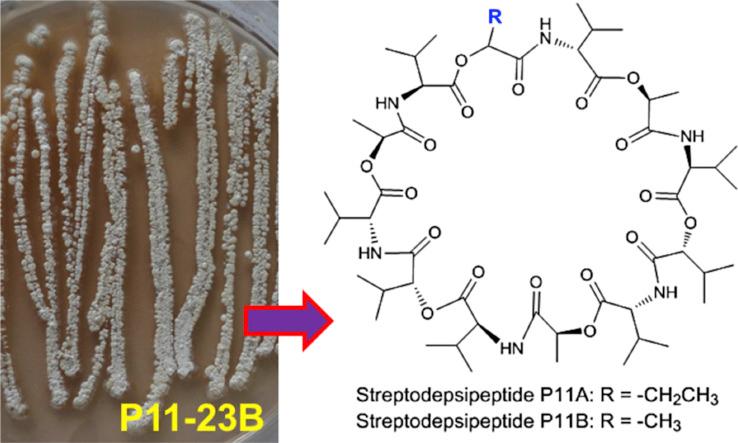
https://cdn.ncbi.nlm.nih.gov/pmc/blobs/35f7/7111624/217782df4c6a/fx1_lrg.jpg

来自海洋放线菌链霉菌属P11-23B的抗增殖环缩肽下调糖酵解、谷氨酰胺分解和脂肪生成的肿瘤代谢酶。
Antiproliferative cyclodepsipeptides from the marine actinomycete Streptomyces sp. P11-23B downregulating the tumor metabolic enzymes of glycolysis, glutaminolysis, and lipogenesis.
作者信息
Ye Xuewei, Anjum Komal, Song Tengfei, Wang Wenling, Liang Ying, Chen Mengxuan, Huang Haocai, Lian Xiao-Yuan, Zhang Zhizhen
机构信息
Ocean College, Zhoushan Campus, Zhejiang University, Zhoushan 316021, China.
College of Pharmaceutical Sciences, Zhejiang University, Hangzhou 310058, China.
出版信息
Phytochemistry. 2017 Mar;135:151-159. doi: 10.1016/j.phytochem.2016.12.010. Epub 2016 Dec 31.
Two cyclodepsipeptides and a known cyclodepsipeptide valinomycin were isolated from a culture of the marine actinomycete Streptomyces sp. P11-23B. Their structures were established based on NMR, HRESIMS, and MS-MS spectroscopic interpretation as well as by chemical degradation. Both streptodepsipeptides P11A and P11B inhibited proliferation of different glioma cell lines, with IC values ranging from 0.1 μM to 1.4 μM. Streptodepsipeptide P11A was found to block the cell cycle at the G/G phase and induce apoptosis in glioma cells. Further investigation demonstrated that streptodepsipeptide P11A downregulated expression of HK2, PFKFB3, PKM2, GLS, and FASN, important tumor metabolic enzymes. Data from this study suggested that targeting multiple tumor metabolic regulators might be one anti-glioma mechanism of streptodepsipeptide P11A. A possible mechanism for this class of streptodepsipeptides is reported herein.
从海洋放线菌链霉菌属菌株P11 - 23B的培养物中分离出两种环缩肽和一种已知的环缩肽缬氨霉素。它们的结构通过核磁共振(NMR)、高分辨电喷雾电离质谱(HRESIMS)、串联质谱(MS - MS)光谱解析以及化学降解得以确定。链缩肽P11A和P11B均能抑制不同胶质瘤细胞系的增殖,其半数抑制浓度(IC)值在0.1 μM至1.4 μM之间。发现链缩肽P11A能使胶质瘤细胞的细胞周期阻滞在G / G期并诱导其凋亡。进一步研究表明,链缩肽P11A下调了HK2、PFKFB3、PKM2、GLS和FASN等重要肿瘤代谢酶的表达。本研究数据表明,靶向多种肿瘤代谢调节因子可能是链缩肽P11A的一种抗胶质瘤机制。本文报道了这类链缩肽的一种可能机制。